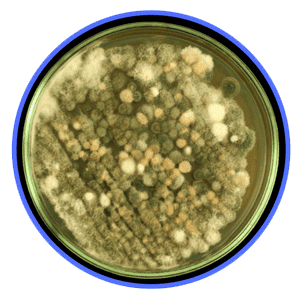

Our Services
Complete Home Inspection

Mold Inspection

Radon Gas Detection

An exhaustive, accurate home inspection can ensure you buy your dream home, not a nightmare property.
We inspect properties thoroughly, using expertise and state of the art technology to deliver reports that help our clients make informed home purchasing decisions.